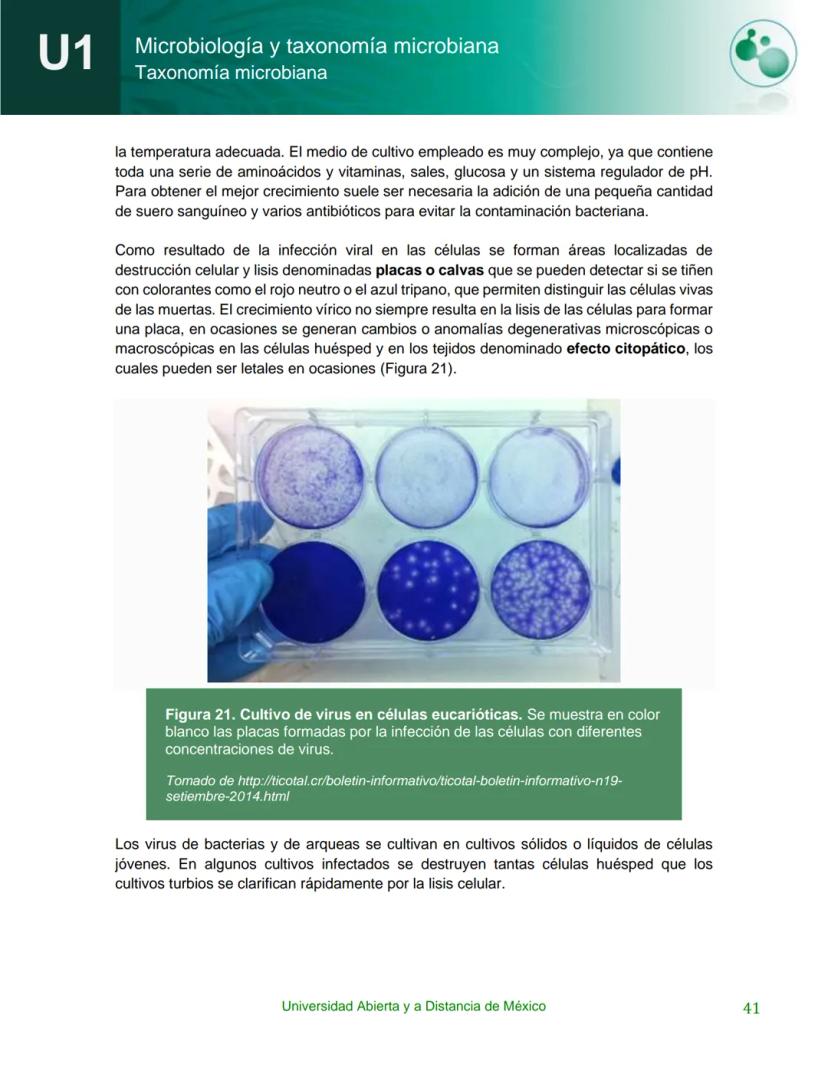
Page 42
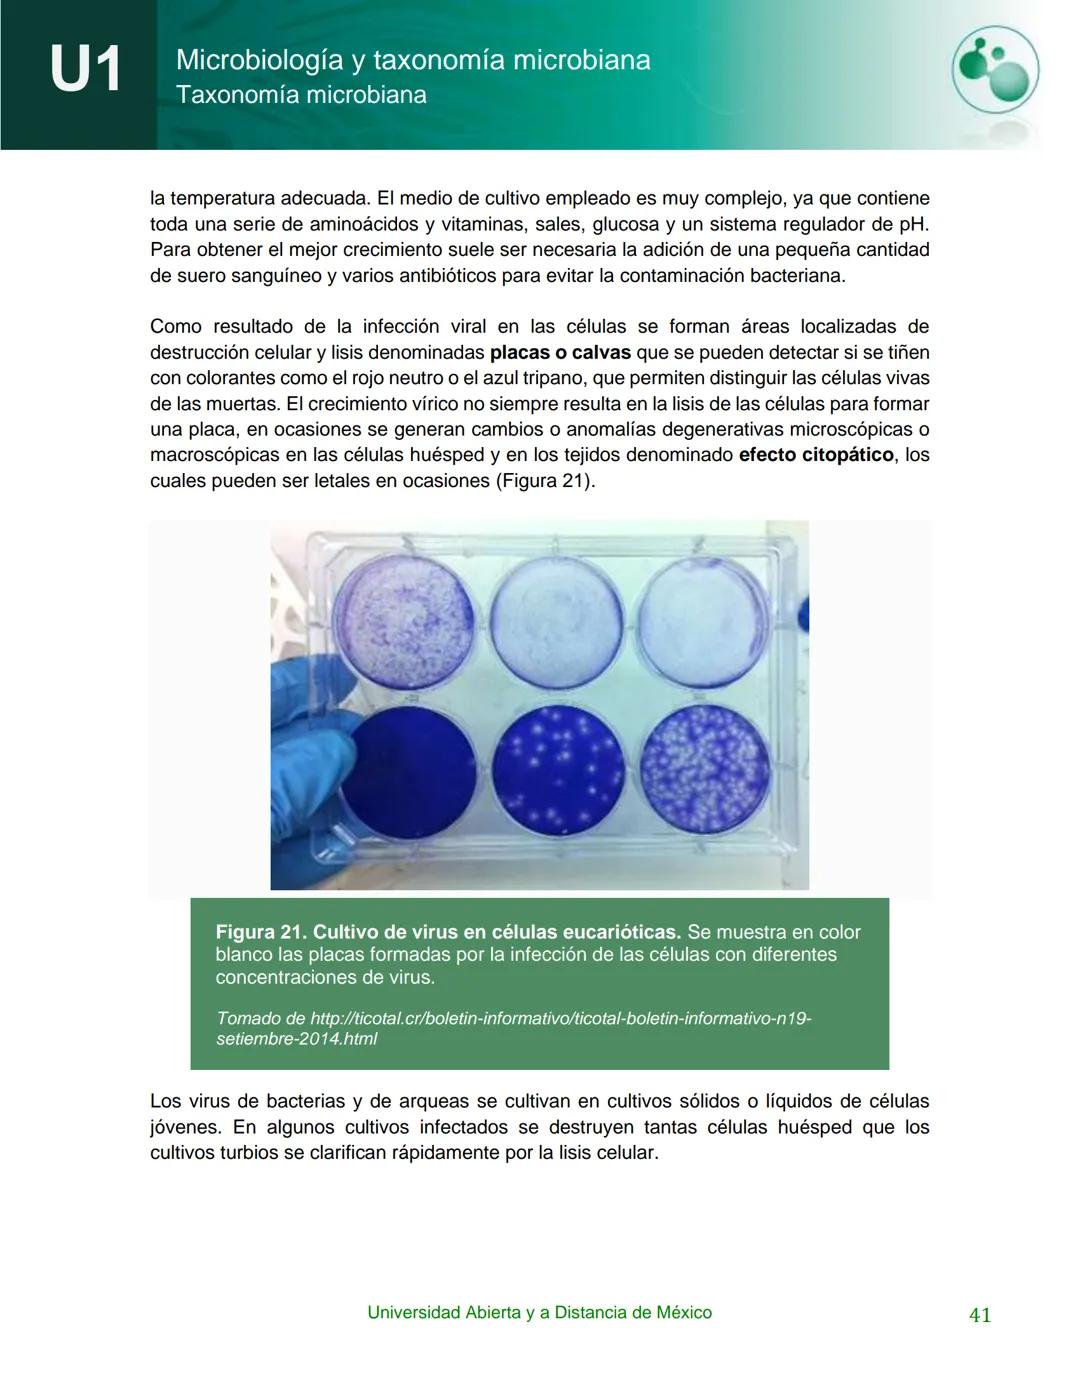
UnADM
UNIVERSIDAD ABIERTA Y
A DISTANCIA DE MÉXICO
Programa de la asignatura:
Microbiología y taxonomía
microbiana
U1 Taxonomía microbiana

La microbiología es una ciencia súper importante para cualquier estudiante... Mostrar más
Inscríbete para ver los apuntes¡Es gratis!
Acceso a todos los documentos
Mejora tus notas
Únete a millones de estudiantes
Knowunity AI
Asignaturas
Triangle Congruence and Similarity Theorems
Triangle Properties and Classification
Linear Equations and Graphs
Geometric Angle Relationships
Trigonometric Functions and Identities
Equation Solving Techniques
Circle Geometry Fundamentals
Division Operations and Methods
Basic Differentiation Rules
Exponent and Logarithm Properties
Mostrar todos los temas
Human Organ Systems
Reproductive Cell Cycles
Biological Sciences Subdisciplines
Cellular Energy Metabolism
Autotrophic Energy Processes
Inheritance Patterns and Principles
Biomolecular Structure and Organization
Cell Cycle and Division Mechanics
Cellular Organization and Development
Biological Structural Organization
Mostrar todos los temas
Chemical Sciences and Applications
Atomic Structure and Composition
Molecular Electron Structure Representation
Atomic Electron Behavior
Matter Properties and Water
Mole Concept and Calculations
Gas Laws and Behavior
Periodic Table Organization
Chemical Thermodynamics Fundamentals
Chemical Bond Types and Properties
Mostrar todos los temas
European Renaissance and Enlightenment
European Cultural Movements 800-1920
American Revolution Era 1763-1797
American Civil War 1861-1865
Global Imperial Systems
Mongol and Chinese Dynasties
U.S. Presidents and World Leaders
Historical Sources and Documentation
World Wars Era and Impact
World Religious Systems
Mostrar todos los temas
Classic and Contemporary Novels
Literary Character Analysis
Rhetorical Theory and Practice
Classic Literary Narratives
Reading Analysis and Interpretation
Narrative Structure and Techniques
English Language Components
Influential English-Language Authors
Basic Sentence Structure
Narrative Voice and Perspective
Mostrar todos los temas
129
•
Actualizado Mar 25, 2026
•
Pablo Gadiel Flores Velasco
@pablogadielflor
La microbiología es una ciencia súper importante para cualquier estudiante... Mostrar más

Esta es la Unidad 1 del curso de Microbiología y taxonomía microbiana de la Universidad Abierta y a Distancia de México. El programa está dirigido a estudiantes de Biotecnología y forma parte del área de Divisiones de Ciencias de la Salud, Biológicas y Ambientales (DCSBA).
💡 Tip clave: Esta unidad te dará las bases fundamentales que necesitas para entender todo el curso de microbiología.

Este es el índice general de la unidad donde encontrarás todos los temas que vamos a cubrir sobre taxonomía microbiana. La estructura está diseñada para llevarte paso a paso desde los conceptos básicos hasta temas más avanzados.
El material está organizado de manera progresiva para que puedas construir tu conocimiento de forma sólida y comprensible.
💡 Recuerda: Tener una visión general del contenido te ayudará a organizar mejor tu tiempo de estudio.

¿Sabías que los microorganismos están literalmente en todas partes y pueden ser tanto tus mejores aliados como tus peores enemigos? Como futuro biotecnólogo, necesitas entender estos pequeños seres porque son fundamentales en todas las áreas del desarrollo humano.
En esta unidad te vas a convertir en un detective microbiano. Aprenderás a usar la taxonomía microbiana como tu herramienta principal para identificar y clasificar microorganismos. Es como aprender el "apellido y nombre" de cada microorganismo que encuentres.
También vas a explorar el controvertido mundo de los virus - esos organismos tan raros que ni siquiera sabemos si están vivos o no. Vas a descubrir cómo se replican, cómo estudiarlos y por qué son tan importantes tanto para causar enfermedades como para la ingeniería genética moderna.
💡 Dato curioso: Los virus son como piratas celulares - necesitan "secuestrar" otras células para poder reproducirse.

Al terminar esta unidad vas a poder hacer cuatro cosas súper importantes: definir qué estudia la microbiología, aplicar las reglas para nombrar microorganismos correctamente, leer árboles filogenéticos como un pro, y explicar cómo funcionan los virus.
La competencia específica que vas a desarrollar es identificar y clasificar microorganismos usando sus características distintivas. Esto significa que podrás diferenciar entre diferentes tipos de microorganismos y entender cómo se relacionan entre sí.
Esta competencia combina tres dimensiones: el saber (conocimientos teóricos), el saber hacer (habilidades prácticas), y el saber ser (actitudes profesionales). Es una competencia integral que te va a servir en toda tu carrera.
💡 Meta personal: Al final de esta unidad, serás capaz de "hablar el idioma" de los microbiólogos profesionales.

Tu viaje de aprendizaje tiene seis paradas importantes. Primero, vas a definir microbiología y taxonomía para tener las bases claras. Segundo, entenderás los criterios que usan los científicos para caracterizar microorganismos.
La tercera parada es dominar los árboles filogenéticos - esas "genealogías" que muestran cómo se relacionan los organismos. Cuarto, aprenderás la diferencia crucial entre especies y cepas de microorganismos.
Las últimas dos paradas se enfocan en los virus: conocer su estructura única y entender paso a paso cómo se replican. Cada objetivo se conecta con el siguiente, creando un aprendizaje progresivo y sólido.
💡 Estrategia de estudio: Domina cada objetivo antes de pasar al siguiente - son como peldaños de una escalera.

La microbiología es literalmente el estudio de la vida pequeña - viene del griego micro (pequeño), bios (vida) y logos (estudio). Estos organismos microscópicos son unos verdaderos sobrevivientes que pueden adaptarse a lugares increíbles como géiseres súper calientes, aguas súper saladas, e incluso dentro de nuestro cuerpo.
Los pioneros Robert Hooke y Antonie van Leeuwenhoek fueron los primeros en descubrir este mundo invisible usando microscopios súper básicos. Imagínate su sorpresa al encontrar toda una civilización microscópica en una gota de agua de lluvia.
Lo increíble de la microbiología es que estudia una diversidad enorme: desde virus (que ni siquiera son células) hasta bacterias, hongos microscópicos y protozoos. Cada uno tiene características únicas pero todos comparten ese tamaño microscópico que los hace invisibles a nuestros ojos.
💡 Conexión real: Los microorganismos participan en ciclos súper importantes como el del nitrógeno y carbono que mantienen funcionando nuestro planeta.

La microbiología no solo estudia cómo se ven los microorganismos, sino también su fisiología, genética, ecología y cómo interactúan con nosotros. Es como estudiar civilizaciones completas pero en versión microscópica.
Esta ciencia se preocupa tanto por los "microbios buenos" que nos ayudan a producir alimentos y medicinas, como por los "microbios malos" que causan enfermedades. Por eso los microbiólogos estudian cómo combatir los patógenos y cómo aprovechar mejor los beneficiosos.
En el siglo XX nacieron muchas subdisciplinas especializadas: la taxonomía microbiana (clasificación), la fisiología microbiana (nutrición y metabolismo), la bioquímica microbiana (reacciones químicas), y la genética microbiana (herencia y variación). Cada una aporta piezas del rompecabezas microbiano.
💡 Aplicación práctica: Estas subdisciplinas trabajan juntas para desarrollar desde antibióticos hasta procesos industriales que usan microorganismos.

La taxonomía viene del griego taxis (ordenamiento) y nomos (regla) - es básicamente el sistema que usan los científicos para poner orden en el caos de la diversidad microbiana. Sin taxonomía, sería como tener una biblioteca gigante sin ningún sistema de organización.
La taxonomía tiene tres partes súper importantes que trabajan juntas. La clasificación agrupa los organismos parecidos, la nomenclatura les pone nombres oficiales, y la identificación te permite reconocer organismos desconocidos comparándolos con los ya conocidos.
Carlos Linneo (el "Padre de la Taxonomía") creó en el siglo XVII el sistema que seguimos usando hoy. Lo genial es que ahora tenemos técnicas moleculares que nos permiten clasificar bacterias no solo por cómo se ven, sino por su ADN.
💡 Ventaja moderna: Las técnicas moleculares están revolucionando la taxonomía porque el ADN no miente - es como tener la huella digital de cada microorganismo.

Clasificar microorganismos es mucho más complicado que clasificar animales o plantas porque la mayoría de las bacterias se ven súper parecidas bajo el microscopio. Los taxónomos tuvieron que ser creativos y buscar características bioquímicas, fisiológicas y ecológicas para diferenciarlas.
La clasificación bacteriana se basa principalmente en lo que hacen, no en cómo se ven. Esto significa que para identificar una bacteria tienes que hacer experimentos para ver qué enzimas produce, qué nutrientes usa, cómo respira, etc.
Las técnicas moleculares están cambiando el juego completamente. Ahora podemos analizar el ADN de las bacterias para clasificarlas de manera más objetiva y precisa. Es como pasar de usar solo fotos en blanco y negro a tener imágenes en 4K.
💡 Evolución científica: La taxonomía microbiana está en constante evolución - lo que aprendemos hoy sobre clasificación puede cambiar mañana con nuevas tecnologías.

Carl von Linneo (1707-1778) fue el científico sueco que revolucionó la manera de nombrar y clasificar a todos los seres vivos, incluyendo los microorganismos. Su sistema de nomenclatura binomial sigue siendo el estándar mundial que usan todos los científicos.
Antes de Linneo, nombrar organismos era un caos total - cada científico usaba nombres diferentes para el mismo organismo. Linneo creó un sistema uniforme que permite a microbiólogos de todo el mundo comunicarse eficazmente usando los mismos nombres científicos.
Su legado es tan importante que sin su sistema, la microbiología moderna sería imposible. Imagínate tratar de estudiar bacterias sin tener nombres estándar para identificarlas.
💡 Legado duradero: Más de 300 años después, seguimos usando el sistema de Linneo - eso sí que es crear algo que perdure en el tiempo.




































Nuestro compañero de IA está específicamente adaptado a las necesidades de los estudiantes. Basándonos en los millones de contenidos que tenemos en la plataforma, podemos dar a los estudiantes respuestas realmente significativas y relevantes. Pero no se trata solo de respuestas, el compañero también guía a los estudiantes a través de sus retos de aprendizaje diarios, con planes de aprendizaje personalizados, cuestionarios o contenidos en el chat y una personalización del 100% basada en las habilidades y el desarrollo de los estudiantes.
Puedes descargar la app en Google Play Store y Apple App Store.
¡Sí lo es! Tienes acceso totalmente gratuito a todo el contenido de la app, puedes chatear con otros alumnos y recibir ayuda inmeditamente. Puedes ganar dinero utilizando la aplicación, que te permitirá acceder a determinadas funciones.
App Store
Google Play
La app es muy fácil de usar y está muy bien diseñada. Hasta ahora he encontrado todo lo que estaba buscando y he podido aprender mucho de las presentaciones. Definitivamente utilizaré la aplicación para un examen de clase. Y, por supuesto, también me sirve mucho de inspiración.
Pablo
usuario de iOS
Esta app es realmente genial. Hay tantos apuntes de clase y ayuda [...]. Tengo problemas con matemáticas, por ejemplo, y la aplicación tiene muchas opciones de ayuda. Gracias a Knowunity, he mejorado en mates. Se la recomiendo a todo el mundo.
Elena
usuaria de Android
Vaya, estoy realmente sorprendida. Acabo de probar la app porque la he visto anunciada muchas veces y me he quedado absolutamente alucinada. Esta app es LA AYUDA que quieres para el insti y, sobre todo, ofrece muchísimas cosas, como ejercicios y hojas informativas, que a mí personalmente me han sido MUY útiles.
Ana
usuaria de iOS
Solía tener dificultades para completar mis tareas a tiempo hasta que descubrí Knowunity, que no solo facilita subir mi propio contenido sino que también proporciona excelentes resúmenes que hacen mi trabajo más rápido y eficiente.
Thomas R
usuario de iOS
Siempre era un desafío encontrar toda la información importante para mis tareas – desde que comencé a usar Knowunity, puedo simplemente subir mi contenido y beneficiarme de los resúmenes de otros, lo que me ayuda mucho con la organización.
Lisa M
usuario de Android
A menudo sentía que no tenía suficiente visión general al estudiar, pero desde que comencé a usar Knowunity, eso ya no es un problema – subo mi contenido y siempre encuentro resúmenes útiles en la plataforma, lo que hace mi aprendizaje mucho más fácil.
David K
usuario de iOS
¡La app es buenísima! Sólo tengo que introducir el tema en la barra de búsqueda y recibo la respuesta muy rápido. No tengo que ver 10 vídeos de YouTube para entender algo, así que me ahorro tiempo. ¡Muy recomendable!
Sara
usuaria de Android
En el instituto era muy malo en matemáticas, pero gracias a la app, ahora saco mejores notas. Os agradezco mucho que hayáis creado la aplicación.
Roberto
usuario de Android
Solía ser muy difícil reunir toda la información para mis presentaciones. Pero desde que comencé a usar Knowunity, solo subo mis notas y encuentro increíbles resúmenes de otros – ¡hace mi estudio mucho más eficiente!
Julia S
usuario de Android
Siempre estaba estresado con todo el material de estudio, pero desde que comencé a usar Knowunity, subo mis cosas y reviso los geniales resúmenes de otros – realmente me ayuda a manejar todo mejor y es mucho menos estresante.
Marco B
usuario de iOS
LOS QUIZZES Y FLASHCARDS SON SÚPER ÚTILES Y AMO Knowunity AI. TAMBIÉN ES LITERALMENTE COMO CHATGPT PERO MÁS INTELIGENTE!! ME AYUDÓ CON MIS PROBLEMAS DE RÍMEL TAMBIÉN!! Y CON MIS MATERIAS REALES OBVIO! 😍😁😲🤑💗✨🎀😮
Sarah L
usuario de Android
Antes pasaba horas buscando en Google materiales escolares, pero ahora solo subo mis cosas a Knowunity y reviso los útiles resúmenes de otros – me siento mucho más seguro cuando me preparo para los exámenes.
Paul T
usuario de iOS
La app es muy fácil de usar y está muy bien diseñada. Hasta ahora he encontrado todo lo que estaba buscando y he podido aprender mucho de las presentaciones. Definitivamente utilizaré la aplicación para un examen de clase. Y, por supuesto, también me sirve mucho de inspiración.
Pablo
usuario de iOS
Esta app es realmente genial. Hay tantos apuntes de clase y ayuda [...]. Tengo problemas con matemáticas, por ejemplo, y la aplicación tiene muchas opciones de ayuda. Gracias a Knowunity, he mejorado en mates. Se la recomiendo a todo el mundo.
Elena
usuaria de Android
Vaya, estoy realmente sorprendida. Acabo de probar la app porque la he visto anunciada muchas veces y me he quedado absolutamente alucinada. Esta app es LA AYUDA que quieres para el insti y, sobre todo, ofrece muchísimas cosas, como ejercicios y hojas informativas, que a mí personalmente me han sido MUY útiles.
Ana
usuaria de iOS
Solía tener dificultades para completar mis tareas a tiempo hasta que descubrí Knowunity, que no solo facilita subir mi propio contenido sino que también proporciona excelentes resúmenes que hacen mi trabajo más rápido y eficiente.
Thomas R
usuario de iOS
Siempre era un desafío encontrar toda la información importante para mis tareas – desde que comencé a usar Knowunity, puedo simplemente subir mi contenido y beneficiarme de los resúmenes de otros, lo que me ayuda mucho con la organización.
Lisa M
usuario de Android
A menudo sentía que no tenía suficiente visión general al estudiar, pero desde que comencé a usar Knowunity, eso ya no es un problema – subo mi contenido y siempre encuentro resúmenes útiles en la plataforma, lo que hace mi aprendizaje mucho más fácil.
David K
usuario de iOS
¡La app es buenísima! Sólo tengo que introducir el tema en la barra de búsqueda y recibo la respuesta muy rápido. No tengo que ver 10 vídeos de YouTube para entender algo, así que me ahorro tiempo. ¡Muy recomendable!
Sara
usuaria de Android
En el instituto era muy malo en matemáticas, pero gracias a la app, ahora saco mejores notas. Os agradezco mucho que hayáis creado la aplicación.
Roberto
usuario de Android
Solía ser muy difícil reunir toda la información para mis presentaciones. Pero desde que comencé a usar Knowunity, solo subo mis notas y encuentro increíbles resúmenes de otros – ¡hace mi estudio mucho más eficiente!
Julia S
usuario de Android
Siempre estaba estresado con todo el material de estudio, pero desde que comencé a usar Knowunity, subo mis cosas y reviso los geniales resúmenes de otros – realmente me ayuda a manejar todo mejor y es mucho menos estresante.
Marco B
usuario de iOS
LOS QUIZZES Y FLASHCARDS SON SÚPER ÚTILES Y AMO Knowunity AI. TAMBIÉN ES LITERALMENTE COMO CHATGPT PERO MÁS INTELIGENTE!! ME AYUDÓ CON MIS PROBLEMAS DE RÍMEL TAMBIÉN!! Y CON MIS MATERIAS REALES OBVIO! 😍😁😲🤑💗✨🎀😮
Sarah L
usuario de Android
Antes pasaba horas buscando en Google materiales escolares, pero ahora solo subo mis cosas a Knowunity y reviso los útiles resúmenes de otros – me siento mucho más seguro cuando me preparo para los exámenes.
Paul T
usuario de iOS
Pablo Gadiel Flores Velasco
@pablogadielflor
La microbiología es una ciencia súper importante para cualquier estudiante de biotecnología porque estudia esos organismos microscópicos que están en todos lados y afectan nuestras vidas de maneras increíbles. En esta unidad vas a aprender cómo los científicos clasifican y... Mostrar más

Acceso a todos los documentos
Mejora tus notas
Únete a millones de estudiantes
Esta es la Unidad 1 del curso de Microbiología y taxonomía microbiana de la Universidad Abierta y a Distancia de México. El programa está dirigido a estudiantes de Biotecnología y forma parte del área de Divisiones de Ciencias de la Salud, Biológicas y Ambientales (DCSBA).
💡 Tip clave: Esta unidad te dará las bases fundamentales que necesitas para entender todo el curso de microbiología.

Acceso a todos los documentos
Mejora tus notas
Únete a millones de estudiantes
Este es el índice general de la unidad donde encontrarás todos los temas que vamos a cubrir sobre taxonomía microbiana. La estructura está diseñada para llevarte paso a paso desde los conceptos básicos hasta temas más avanzados.
El material está organizado de manera progresiva para que puedas construir tu conocimiento de forma sólida y comprensible.
💡 Recuerda: Tener una visión general del contenido te ayudará a organizar mejor tu tiempo de estudio.

Acceso a todos los documentos
Mejora tus notas
Únete a millones de estudiantes
¿Sabías que los microorganismos están literalmente en todas partes y pueden ser tanto tus mejores aliados como tus peores enemigos? Como futuro biotecnólogo, necesitas entender estos pequeños seres porque son fundamentales en todas las áreas del desarrollo humano.
En esta unidad te vas a convertir en un detective microbiano. Aprenderás a usar la taxonomía microbiana como tu herramienta principal para identificar y clasificar microorganismos. Es como aprender el "apellido y nombre" de cada microorganismo que encuentres.
También vas a explorar el controvertido mundo de los virus - esos organismos tan raros que ni siquiera sabemos si están vivos o no. Vas a descubrir cómo se replican, cómo estudiarlos y por qué son tan importantes tanto para causar enfermedades como para la ingeniería genética moderna.
💡 Dato curioso: Los virus son como piratas celulares - necesitan "secuestrar" otras células para poder reproducirse.

Acceso a todos los documentos
Mejora tus notas
Únete a millones de estudiantes
Al terminar esta unidad vas a poder hacer cuatro cosas súper importantes: definir qué estudia la microbiología, aplicar las reglas para nombrar microorganismos correctamente, leer árboles filogenéticos como un pro, y explicar cómo funcionan los virus.
La competencia específica que vas a desarrollar es identificar y clasificar microorganismos usando sus características distintivas. Esto significa que podrás diferenciar entre diferentes tipos de microorganismos y entender cómo se relacionan entre sí.
Esta competencia combina tres dimensiones: el saber (conocimientos teóricos), el saber hacer (habilidades prácticas), y el saber ser (actitudes profesionales). Es una competencia integral que te va a servir en toda tu carrera.
💡 Meta personal: Al final de esta unidad, serás capaz de "hablar el idioma" de los microbiólogos profesionales.

Acceso a todos los documentos
Mejora tus notas
Únete a millones de estudiantes
Tu viaje de aprendizaje tiene seis paradas importantes. Primero, vas a definir microbiología y taxonomía para tener las bases claras. Segundo, entenderás los criterios que usan los científicos para caracterizar microorganismos.
La tercera parada es dominar los árboles filogenéticos - esas "genealogías" que muestran cómo se relacionan los organismos. Cuarto, aprenderás la diferencia crucial entre especies y cepas de microorganismos.
Las últimas dos paradas se enfocan en los virus: conocer su estructura única y entender paso a paso cómo se replican. Cada objetivo se conecta con el siguiente, creando un aprendizaje progresivo y sólido.
💡 Estrategia de estudio: Domina cada objetivo antes de pasar al siguiente - son como peldaños de una escalera.

Acceso a todos los documentos
Mejora tus notas
Únete a millones de estudiantes
La microbiología es literalmente el estudio de la vida pequeña - viene del griego micro (pequeño), bios (vida) y logos (estudio). Estos organismos microscópicos son unos verdaderos sobrevivientes que pueden adaptarse a lugares increíbles como géiseres súper calientes, aguas súper saladas, e incluso dentro de nuestro cuerpo.
Los pioneros Robert Hooke y Antonie van Leeuwenhoek fueron los primeros en descubrir este mundo invisible usando microscopios súper básicos. Imagínate su sorpresa al encontrar toda una civilización microscópica en una gota de agua de lluvia.
Lo increíble de la microbiología es que estudia una diversidad enorme: desde virus (que ni siquiera son células) hasta bacterias, hongos microscópicos y protozoos. Cada uno tiene características únicas pero todos comparten ese tamaño microscópico que los hace invisibles a nuestros ojos.
💡 Conexión real: Los microorganismos participan en ciclos súper importantes como el del nitrógeno y carbono que mantienen funcionando nuestro planeta.

Acceso a todos los documentos
Mejora tus notas
Únete a millones de estudiantes
La microbiología no solo estudia cómo se ven los microorganismos, sino también su fisiología, genética, ecología y cómo interactúan con nosotros. Es como estudiar civilizaciones completas pero en versión microscópica.
Esta ciencia se preocupa tanto por los "microbios buenos" que nos ayudan a producir alimentos y medicinas, como por los "microbios malos" que causan enfermedades. Por eso los microbiólogos estudian cómo combatir los patógenos y cómo aprovechar mejor los beneficiosos.
En el siglo XX nacieron muchas subdisciplinas especializadas: la taxonomía microbiana (clasificación), la fisiología microbiana (nutrición y metabolismo), la bioquímica microbiana (reacciones químicas), y la genética microbiana (herencia y variación). Cada una aporta piezas del rompecabezas microbiano.
💡 Aplicación práctica: Estas subdisciplinas trabajan juntas para desarrollar desde antibióticos hasta procesos industriales que usan microorganismos.

Acceso a todos los documentos
Mejora tus notas
Únete a millones de estudiantes
La taxonomía viene del griego taxis (ordenamiento) y nomos (regla) - es básicamente el sistema que usan los científicos para poner orden en el caos de la diversidad microbiana. Sin taxonomía, sería como tener una biblioteca gigante sin ningún sistema de organización.
La taxonomía tiene tres partes súper importantes que trabajan juntas. La clasificación agrupa los organismos parecidos, la nomenclatura les pone nombres oficiales, y la identificación te permite reconocer organismos desconocidos comparándolos con los ya conocidos.
Carlos Linneo (el "Padre de la Taxonomía") creó en el siglo XVII el sistema que seguimos usando hoy. Lo genial es que ahora tenemos técnicas moleculares que nos permiten clasificar bacterias no solo por cómo se ven, sino por su ADN.
💡 Ventaja moderna: Las técnicas moleculares están revolucionando la taxonomía porque el ADN no miente - es como tener la huella digital de cada microorganismo.

Acceso a todos los documentos
Mejora tus notas
Únete a millones de estudiantes
Clasificar microorganismos es mucho más complicado que clasificar animales o plantas porque la mayoría de las bacterias se ven súper parecidas bajo el microscopio. Los taxónomos tuvieron que ser creativos y buscar características bioquímicas, fisiológicas y ecológicas para diferenciarlas.
La clasificación bacteriana se basa principalmente en lo que hacen, no en cómo se ven. Esto significa que para identificar una bacteria tienes que hacer experimentos para ver qué enzimas produce, qué nutrientes usa, cómo respira, etc.
Las técnicas moleculares están cambiando el juego completamente. Ahora podemos analizar el ADN de las bacterias para clasificarlas de manera más objetiva y precisa. Es como pasar de usar solo fotos en blanco y negro a tener imágenes en 4K.
💡 Evolución científica: La taxonomía microbiana está en constante evolución - lo que aprendemos hoy sobre clasificación puede cambiar mañana con nuevas tecnologías.

Acceso a todos los documentos
Mejora tus notas
Únete a millones de estudiantes
Carl von Linneo (1707-1778) fue el científico sueco que revolucionó la manera de nombrar y clasificar a todos los seres vivos, incluyendo los microorganismos. Su sistema de nomenclatura binomial sigue siendo el estándar mundial que usan todos los científicos.
Antes de Linneo, nombrar organismos era un caos total - cada científico usaba nombres diferentes para el mismo organismo. Linneo creó un sistema uniforme que permite a microbiólogos de todo el mundo comunicarse eficazmente usando los mismos nombres científicos.
Su legado es tan importante que sin su sistema, la microbiología moderna sería imposible. Imagínate tratar de estudiar bacterias sin tener nombres estándar para identificarlas.
💡 Legado duradero: Más de 300 años después, seguimos usando el sistema de Linneo - eso sí que es crear algo que perdure en el tiempo.

Acceso a todos los documentos
Mejora tus notas
Únete a millones de estudiantes

Acceso a todos los documentos
Mejora tus notas
Únete a millones de estudiantes

Acceso a todos los documentos
Mejora tus notas
Únete a millones de estudiantes

Acceso a todos los documentos
Mejora tus notas
Únete a millones de estudiantes

Acceso a todos los documentos
Mejora tus notas
Únete a millones de estudiantes

Acceso a todos los documentos
Mejora tus notas
Únete a millones de estudiantes

Acceso a todos los documentos
Mejora tus notas
Únete a millones de estudiantes

Acceso a todos los documentos
Mejora tus notas
Únete a millones de estudiantes

Acceso a todos los documentos
Mejora tus notas
Únete a millones de estudiantes

Acceso a todos los documentos
Mejora tus notas
Únete a millones de estudiantes

Acceso a todos los documentos
Mejora tus notas
Únete a millones de estudiantes

Acceso a todos los documentos
Mejora tus notas
Únete a millones de estudiantes

Acceso a todos los documentos
Mejora tus notas
Únete a millones de estudiantes

Acceso a todos los documentos
Mejora tus notas
Únete a millones de estudiantes

Acceso a todos los documentos
Mejora tus notas
Únete a millones de estudiantes

Acceso a todos los documentos
Mejora tus notas
Únete a millones de estudiantes

Acceso a todos los documentos
Mejora tus notas
Únete a millones de estudiantes

Acceso a todos los documentos
Mejora tus notas
Únete a millones de estudiantes

Acceso a todos los documentos
Mejora tus notas
Únete a millones de estudiantes

Acceso a todos los documentos
Mejora tus notas
Únete a millones de estudiantes

Acceso a todos los documentos
Mejora tus notas
Únete a millones de estudiantes

Acceso a todos los documentos
Mejora tus notas
Únete a millones de estudiantes

Acceso a todos los documentos
Mejora tus notas
Únete a millones de estudiantes

Acceso a todos los documentos
Mejora tus notas
Únete a millones de estudiantes

Acceso a todos los documentos
Mejora tus notas
Únete a millones de estudiantes

Acceso a todos los documentos
Mejora tus notas
Únete a millones de estudiantes

Acceso a todos los documentos
Mejora tus notas
Únete a millones de estudiantes

Acceso a todos los documentos
Mejora tus notas
Únete a millones de estudiantes

Acceso a todos los documentos
Mejora tus notas
Únete a millones de estudiantes

Acceso a todos los documentos
Mejora tus notas
Únete a millones de estudiantes

Acceso a todos los documentos
Mejora tus notas
Únete a millones de estudiantes
Acceso a todos los documentos
Mejora tus notas
Únete a millones de estudiantes

Acceso a todos los documentos
Mejora tus notas
Únete a millones de estudiantes

Acceso a todos los documentos
Mejora tus notas
Únete a millones de estudiantes

Acceso a todos los documentos
Mejora tus notas
Únete a millones de estudiantes

Acceso a todos los documentos
Mejora tus notas
Únete a millones de estudiantes
Nuestro compañero de IA está específicamente adaptado a las necesidades de los estudiantes. Basándonos en los millones de contenidos que tenemos en la plataforma, podemos dar a los estudiantes respuestas realmente significativas y relevantes. Pero no se trata solo de respuestas, el compañero también guía a los estudiantes a través de sus retos de aprendizaje diarios, con planes de aprendizaje personalizados, cuestionarios o contenidos en el chat y una personalización del 100% basada en las habilidades y el desarrollo de los estudiantes.
Puedes descargar la app en Google Play Store y Apple App Store.
¡Sí lo es! Tienes acceso totalmente gratuito a todo el contenido de la app, puedes chatear con otros alumnos y recibir ayuda inmeditamente. Puedes ganar dinero utilizando la aplicación, que te permitirá acceder a determinadas funciones.
0
Herramientas Inteligentes NUEVO
Convierte estos apuntes en: ✓ 50+ Preguntas de Práctica ✓ Tarjetas de Estudio Interactivas ✓ Examen Completo de Práctica ✓ Esquemas de Ensayo
App Store
Google Play
La app es muy fácil de usar y está muy bien diseñada. Hasta ahora he encontrado todo lo que estaba buscando y he podido aprender mucho de las presentaciones. Definitivamente utilizaré la aplicación para un examen de clase. Y, por supuesto, también me sirve mucho de inspiración.
Pablo
usuario de iOS
Esta app es realmente genial. Hay tantos apuntes de clase y ayuda [...]. Tengo problemas con matemáticas, por ejemplo, y la aplicación tiene muchas opciones de ayuda. Gracias a Knowunity, he mejorado en mates. Se la recomiendo a todo el mundo.
Elena
usuaria de Android
Vaya, estoy realmente sorprendida. Acabo de probar la app porque la he visto anunciada muchas veces y me he quedado absolutamente alucinada. Esta app es LA AYUDA que quieres para el insti y, sobre todo, ofrece muchísimas cosas, como ejercicios y hojas informativas, que a mí personalmente me han sido MUY útiles.
Ana
usuaria de iOS
Solía tener dificultades para completar mis tareas a tiempo hasta que descubrí Knowunity, que no solo facilita subir mi propio contenido sino que también proporciona excelentes resúmenes que hacen mi trabajo más rápido y eficiente.
Thomas R
usuario de iOS
Siempre era un desafío encontrar toda la información importante para mis tareas – desde que comencé a usar Knowunity, puedo simplemente subir mi contenido y beneficiarme de los resúmenes de otros, lo que me ayuda mucho con la organización.
Lisa M
usuario de Android
A menudo sentía que no tenía suficiente visión general al estudiar, pero desde que comencé a usar Knowunity, eso ya no es un problema – subo mi contenido y siempre encuentro resúmenes útiles en la plataforma, lo que hace mi aprendizaje mucho más fácil.
David K
usuario de iOS
¡La app es buenísima! Sólo tengo que introducir el tema en la barra de búsqueda y recibo la respuesta muy rápido. No tengo que ver 10 vídeos de YouTube para entender algo, así que me ahorro tiempo. ¡Muy recomendable!
Sara
usuaria de Android
En el instituto era muy malo en matemáticas, pero gracias a la app, ahora saco mejores notas. Os agradezco mucho que hayáis creado la aplicación.
Roberto
usuario de Android
Solía ser muy difícil reunir toda la información para mis presentaciones. Pero desde que comencé a usar Knowunity, solo subo mis notas y encuentro increíbles resúmenes de otros – ¡hace mi estudio mucho más eficiente!
Julia S
usuario de Android
Siempre estaba estresado con todo el material de estudio, pero desde que comencé a usar Knowunity, subo mis cosas y reviso los geniales resúmenes de otros – realmente me ayuda a manejar todo mejor y es mucho menos estresante.
Marco B
usuario de iOS
LOS QUIZZES Y FLASHCARDS SON SÚPER ÚTILES Y AMO Knowunity AI. TAMBIÉN ES LITERALMENTE COMO CHATGPT PERO MÁS INTELIGENTE!! ME AYUDÓ CON MIS PROBLEMAS DE RÍMEL TAMBIÉN!! Y CON MIS MATERIAS REALES OBVIO! 😍😁😲🤑💗✨🎀😮
Sarah L
usuario de Android
Antes pasaba horas buscando en Google materiales escolares, pero ahora solo subo mis cosas a Knowunity y reviso los útiles resúmenes de otros – me siento mucho más seguro cuando me preparo para los exámenes.
Paul T
usuario de iOS
La app es muy fácil de usar y está muy bien diseñada. Hasta ahora he encontrado todo lo que estaba buscando y he podido aprender mucho de las presentaciones. Definitivamente utilizaré la aplicación para un examen de clase. Y, por supuesto, también me sirve mucho de inspiración.
Pablo
usuario de iOS
Esta app es realmente genial. Hay tantos apuntes de clase y ayuda [...]. Tengo problemas con matemáticas, por ejemplo, y la aplicación tiene muchas opciones de ayuda. Gracias a Knowunity, he mejorado en mates. Se la recomiendo a todo el mundo.
Elena
usuaria de Android
Vaya, estoy realmente sorprendida. Acabo de probar la app porque la he visto anunciada muchas veces y me he quedado absolutamente alucinada. Esta app es LA AYUDA que quieres para el insti y, sobre todo, ofrece muchísimas cosas, como ejercicios y hojas informativas, que a mí personalmente me han sido MUY útiles.
Ana
usuaria de iOS
Solía tener dificultades para completar mis tareas a tiempo hasta que descubrí Knowunity, que no solo facilita subir mi propio contenido sino que también proporciona excelentes resúmenes que hacen mi trabajo más rápido y eficiente.
Thomas R
usuario de iOS
Siempre era un desafío encontrar toda la información importante para mis tareas – desde que comencé a usar Knowunity, puedo simplemente subir mi contenido y beneficiarme de los resúmenes de otros, lo que me ayuda mucho con la organización.
Lisa M
usuario de Android
A menudo sentía que no tenía suficiente visión general al estudiar, pero desde que comencé a usar Knowunity, eso ya no es un problema – subo mi contenido y siempre encuentro resúmenes útiles en la plataforma, lo que hace mi aprendizaje mucho más fácil.
David K
usuario de iOS
¡La app es buenísima! Sólo tengo que introducir el tema en la barra de búsqueda y recibo la respuesta muy rápido. No tengo que ver 10 vídeos de YouTube para entender algo, así que me ahorro tiempo. ¡Muy recomendable!
Sara
usuaria de Android
En el instituto era muy malo en matemáticas, pero gracias a la app, ahora saco mejores notas. Os agradezco mucho que hayáis creado la aplicación.
Roberto
usuario de Android
Solía ser muy difícil reunir toda la información para mis presentaciones. Pero desde que comencé a usar Knowunity, solo subo mis notas y encuentro increíbles resúmenes de otros – ¡hace mi estudio mucho más eficiente!
Julia S
usuario de Android
Siempre estaba estresado con todo el material de estudio, pero desde que comencé a usar Knowunity, subo mis cosas y reviso los geniales resúmenes de otros – realmente me ayuda a manejar todo mejor y es mucho menos estresante.
Marco B
usuario de iOS
LOS QUIZZES Y FLASHCARDS SON SÚPER ÚTILES Y AMO Knowunity AI. TAMBIÉN ES LITERALMENTE COMO CHATGPT PERO MÁS INTELIGENTE!! ME AYUDÓ CON MIS PROBLEMAS DE RÍMEL TAMBIÉN!! Y CON MIS MATERIAS REALES OBVIO! 😍😁😲🤑💗✨🎀😮
Sarah L
usuario de Android
Antes pasaba horas buscando en Google materiales escolares, pero ahora solo subo mis cosas a Knowunity y reviso los útiles resúmenes de otros – me siento mucho más seguro cuando me preparo para los exámenes.
Paul T
usuario de iOS